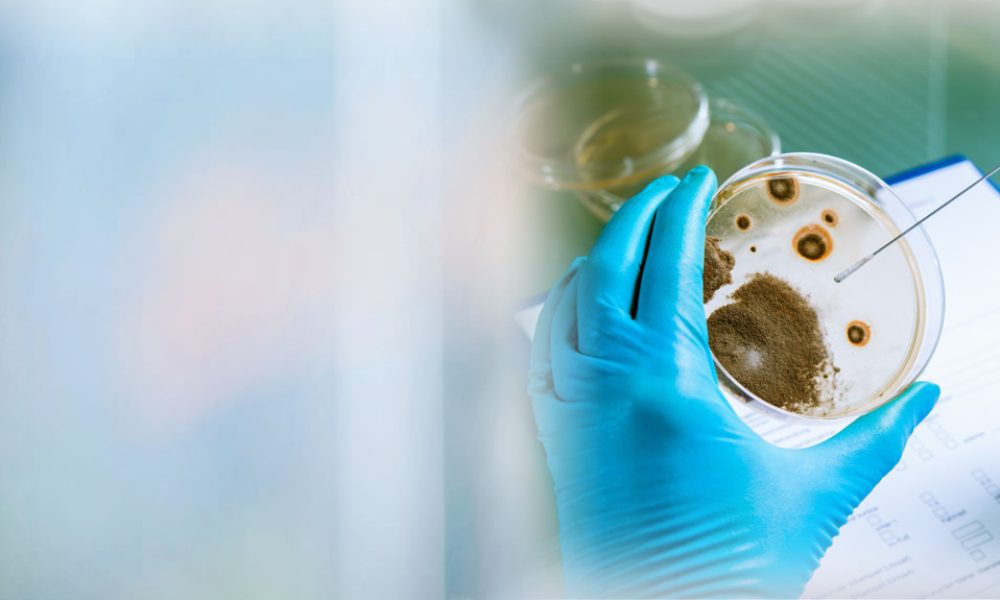
Moldxperts

Loading…
Address
Address:
3180 NE 48th Ct, Lighthouse Point, FL 33064, USA
Telephone:
Opening Hours
Open
Monday
Open 24 hours
Tuesday
Open 24 hours
Wednesday
Open 24 hours
Thursday
Open 24 hours
Friday
Open 24 hours
Saturday
Open 24 hours
Sunday
Open 24 hours
Click on button to show the map.
Got Mold? Always feeling sick? Let MoldXperts inspect your home, condo, or office and help get you back to living a healthier life.